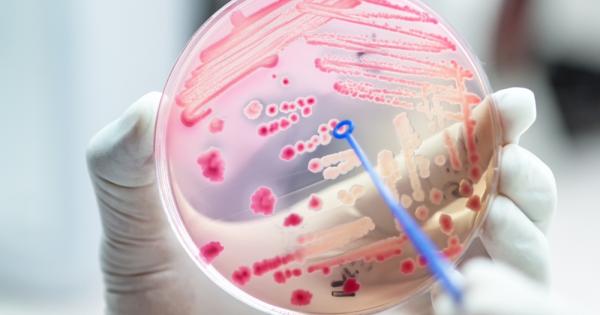
Ново изследване показва че в по голямата част на Европа резистентността

... комплименти от партньорите на инициативата, сред които ваучери за безплатни изследвания и седмични карти за фитнес. Кампаниятасе организира от,в партньорство с,, и с подкрепата на,,,,,.
Резистентност През - Новини
Повече от три милиона деца много от тях от Югоизточна
...... ефективни протоколи за лечение, добави той. „Разглеждането на този въпрос изисква спешни и координирани действия както на регионално, така и на глобално ниво“, добави проучването.
Нарастващата антимикробна резистентност може да причини до 40 милиона случая
...... пъти по-голям от този на обикновените вируси. Тези вируси имат много сложен геном: те практически са лишени от гени, които присъстват в други групи вируси.
Ново изследване показва че в по голямата част на Европа резистентността
...... скорост, намалената ефективност на сегашните медикаменти ще продължи да води до все така високи нива на рак на стомаха и други заболявания като язва." Източник: IFLScience
Смъртните случаи в САЩ от инфекции причинени от бактерии резистентни
...... е и начин да се създадат условия за по-добър контрол на бактериалните инфекции и ограничаване на прекомерната употреба на антибиотици, която води до антимикробна резистентност.
Повече от 1 2 милиона души са починали по света през
...... и на този проблем трябва да се погледне сериозна – това е и призивът към политическите и здравните лидери навсякъде по света“, добави д-р Лаксминараян.